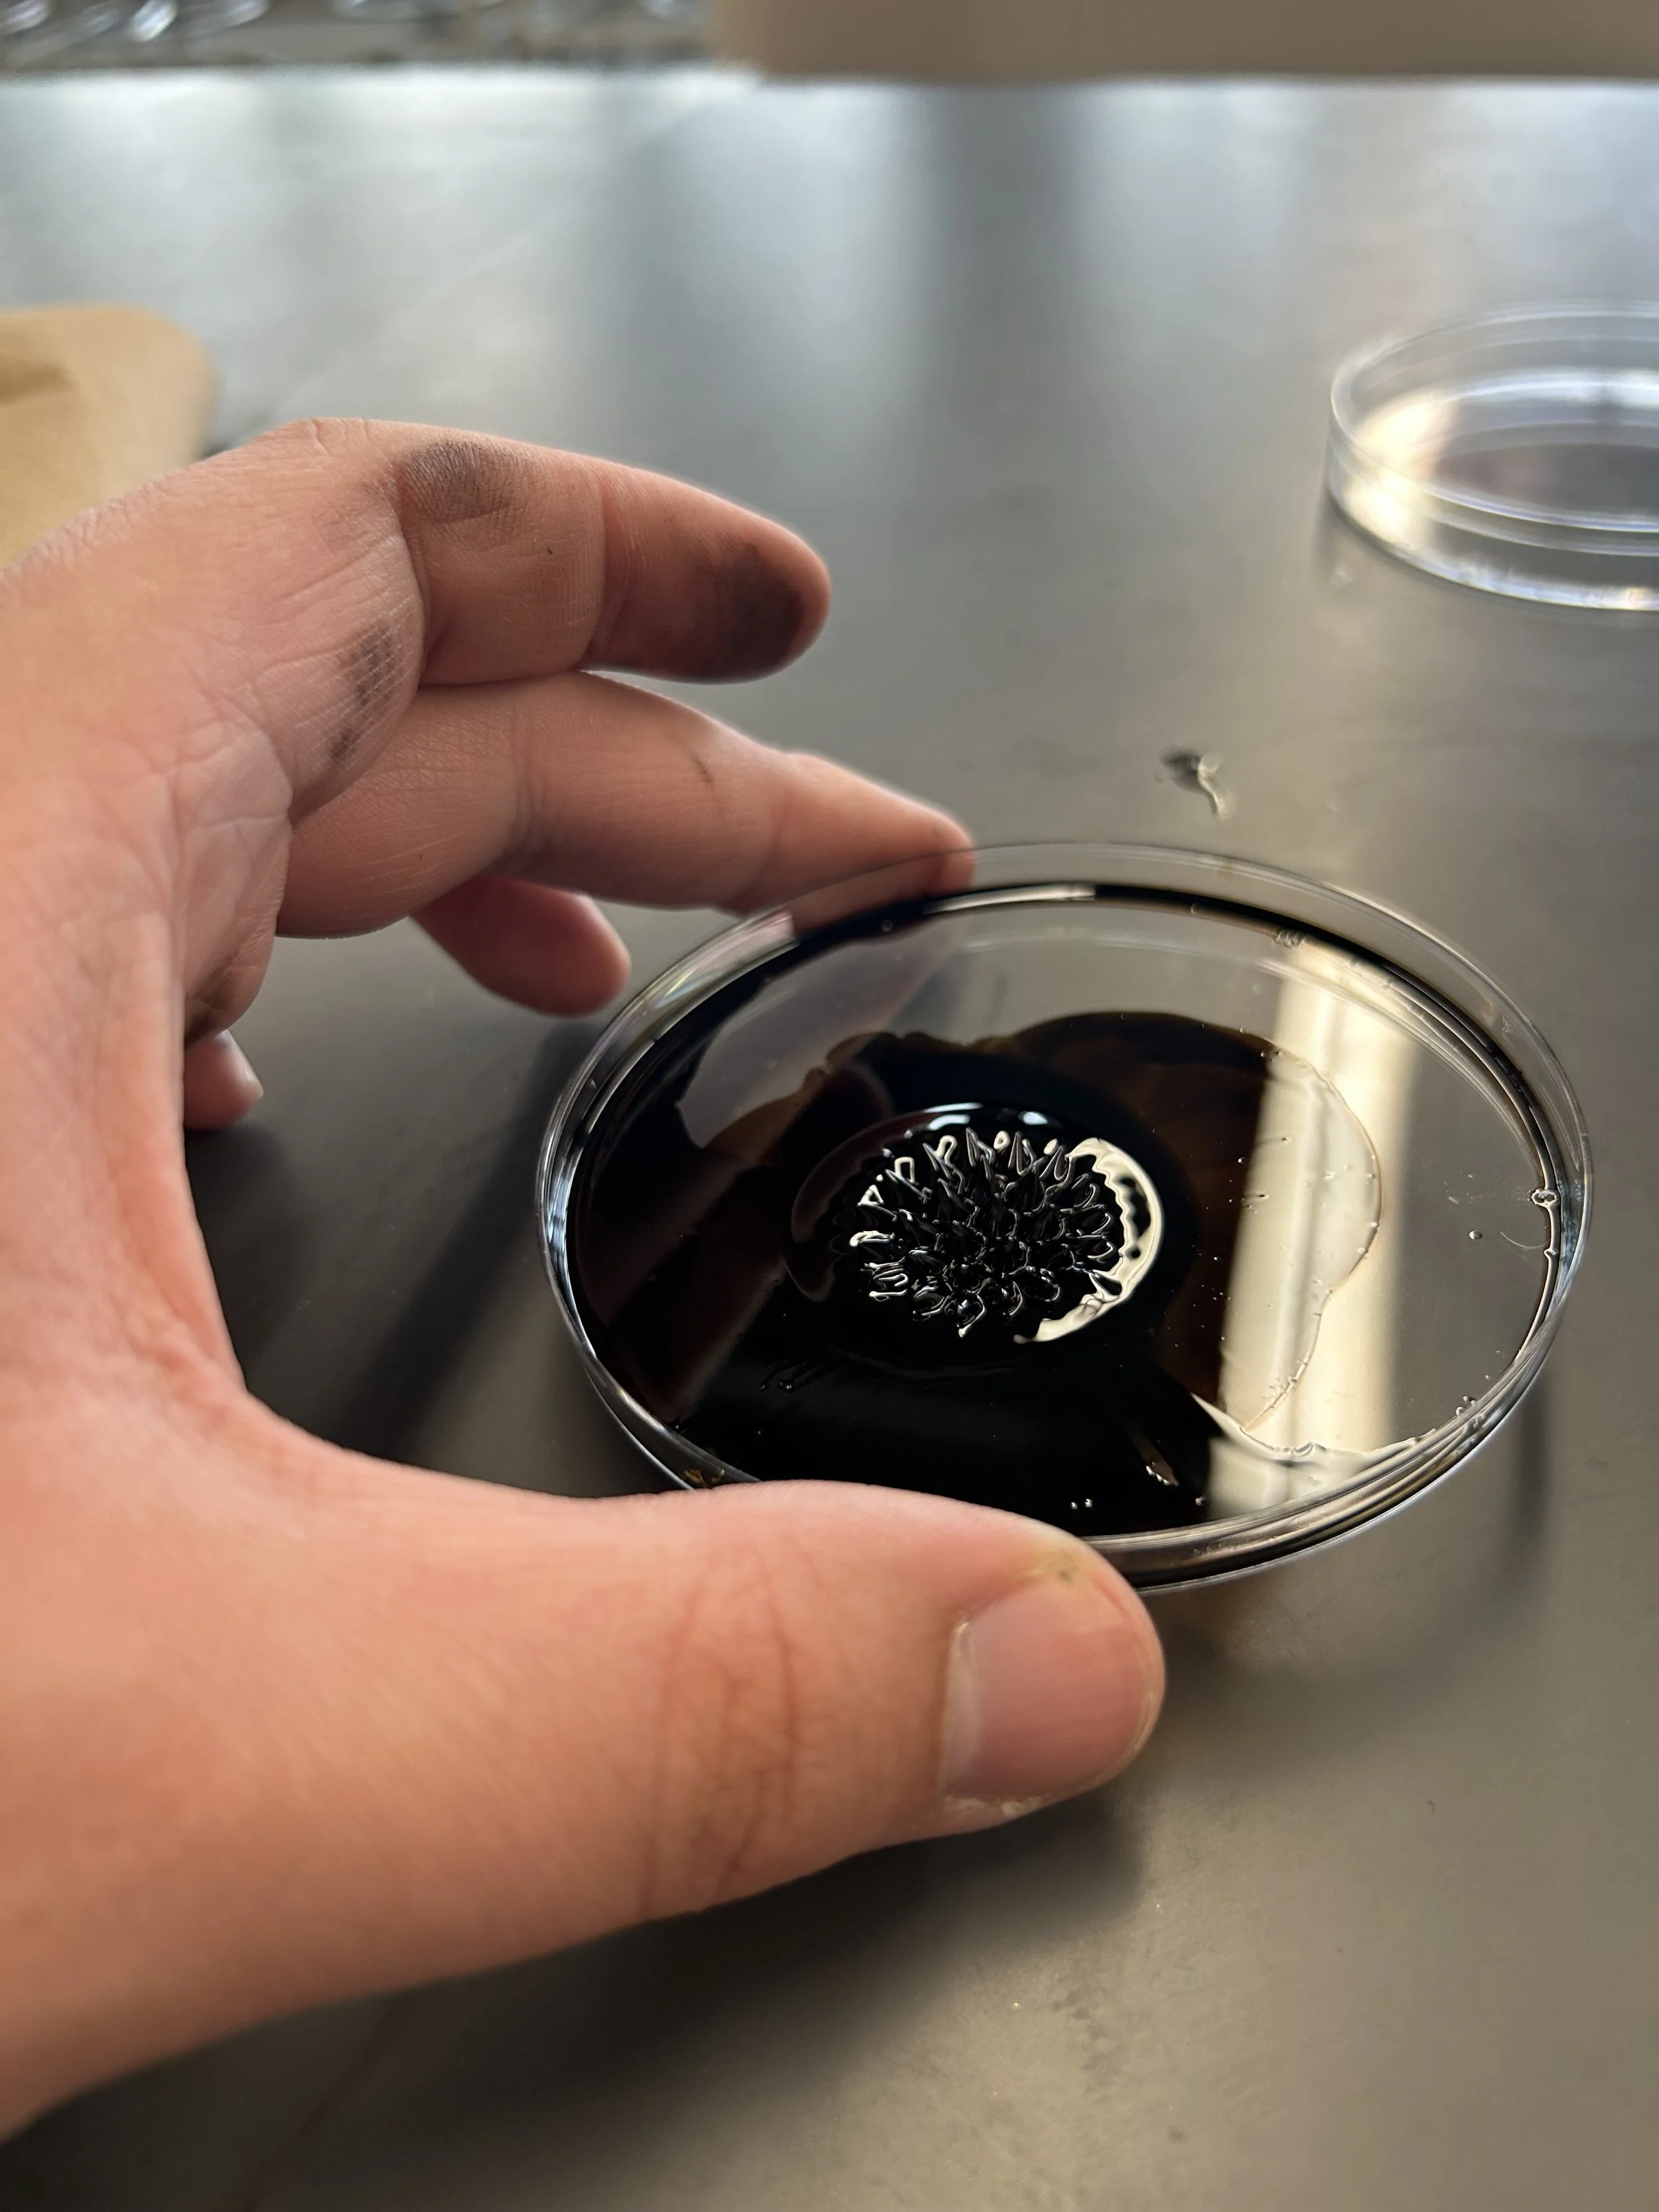
Ferrofluid A
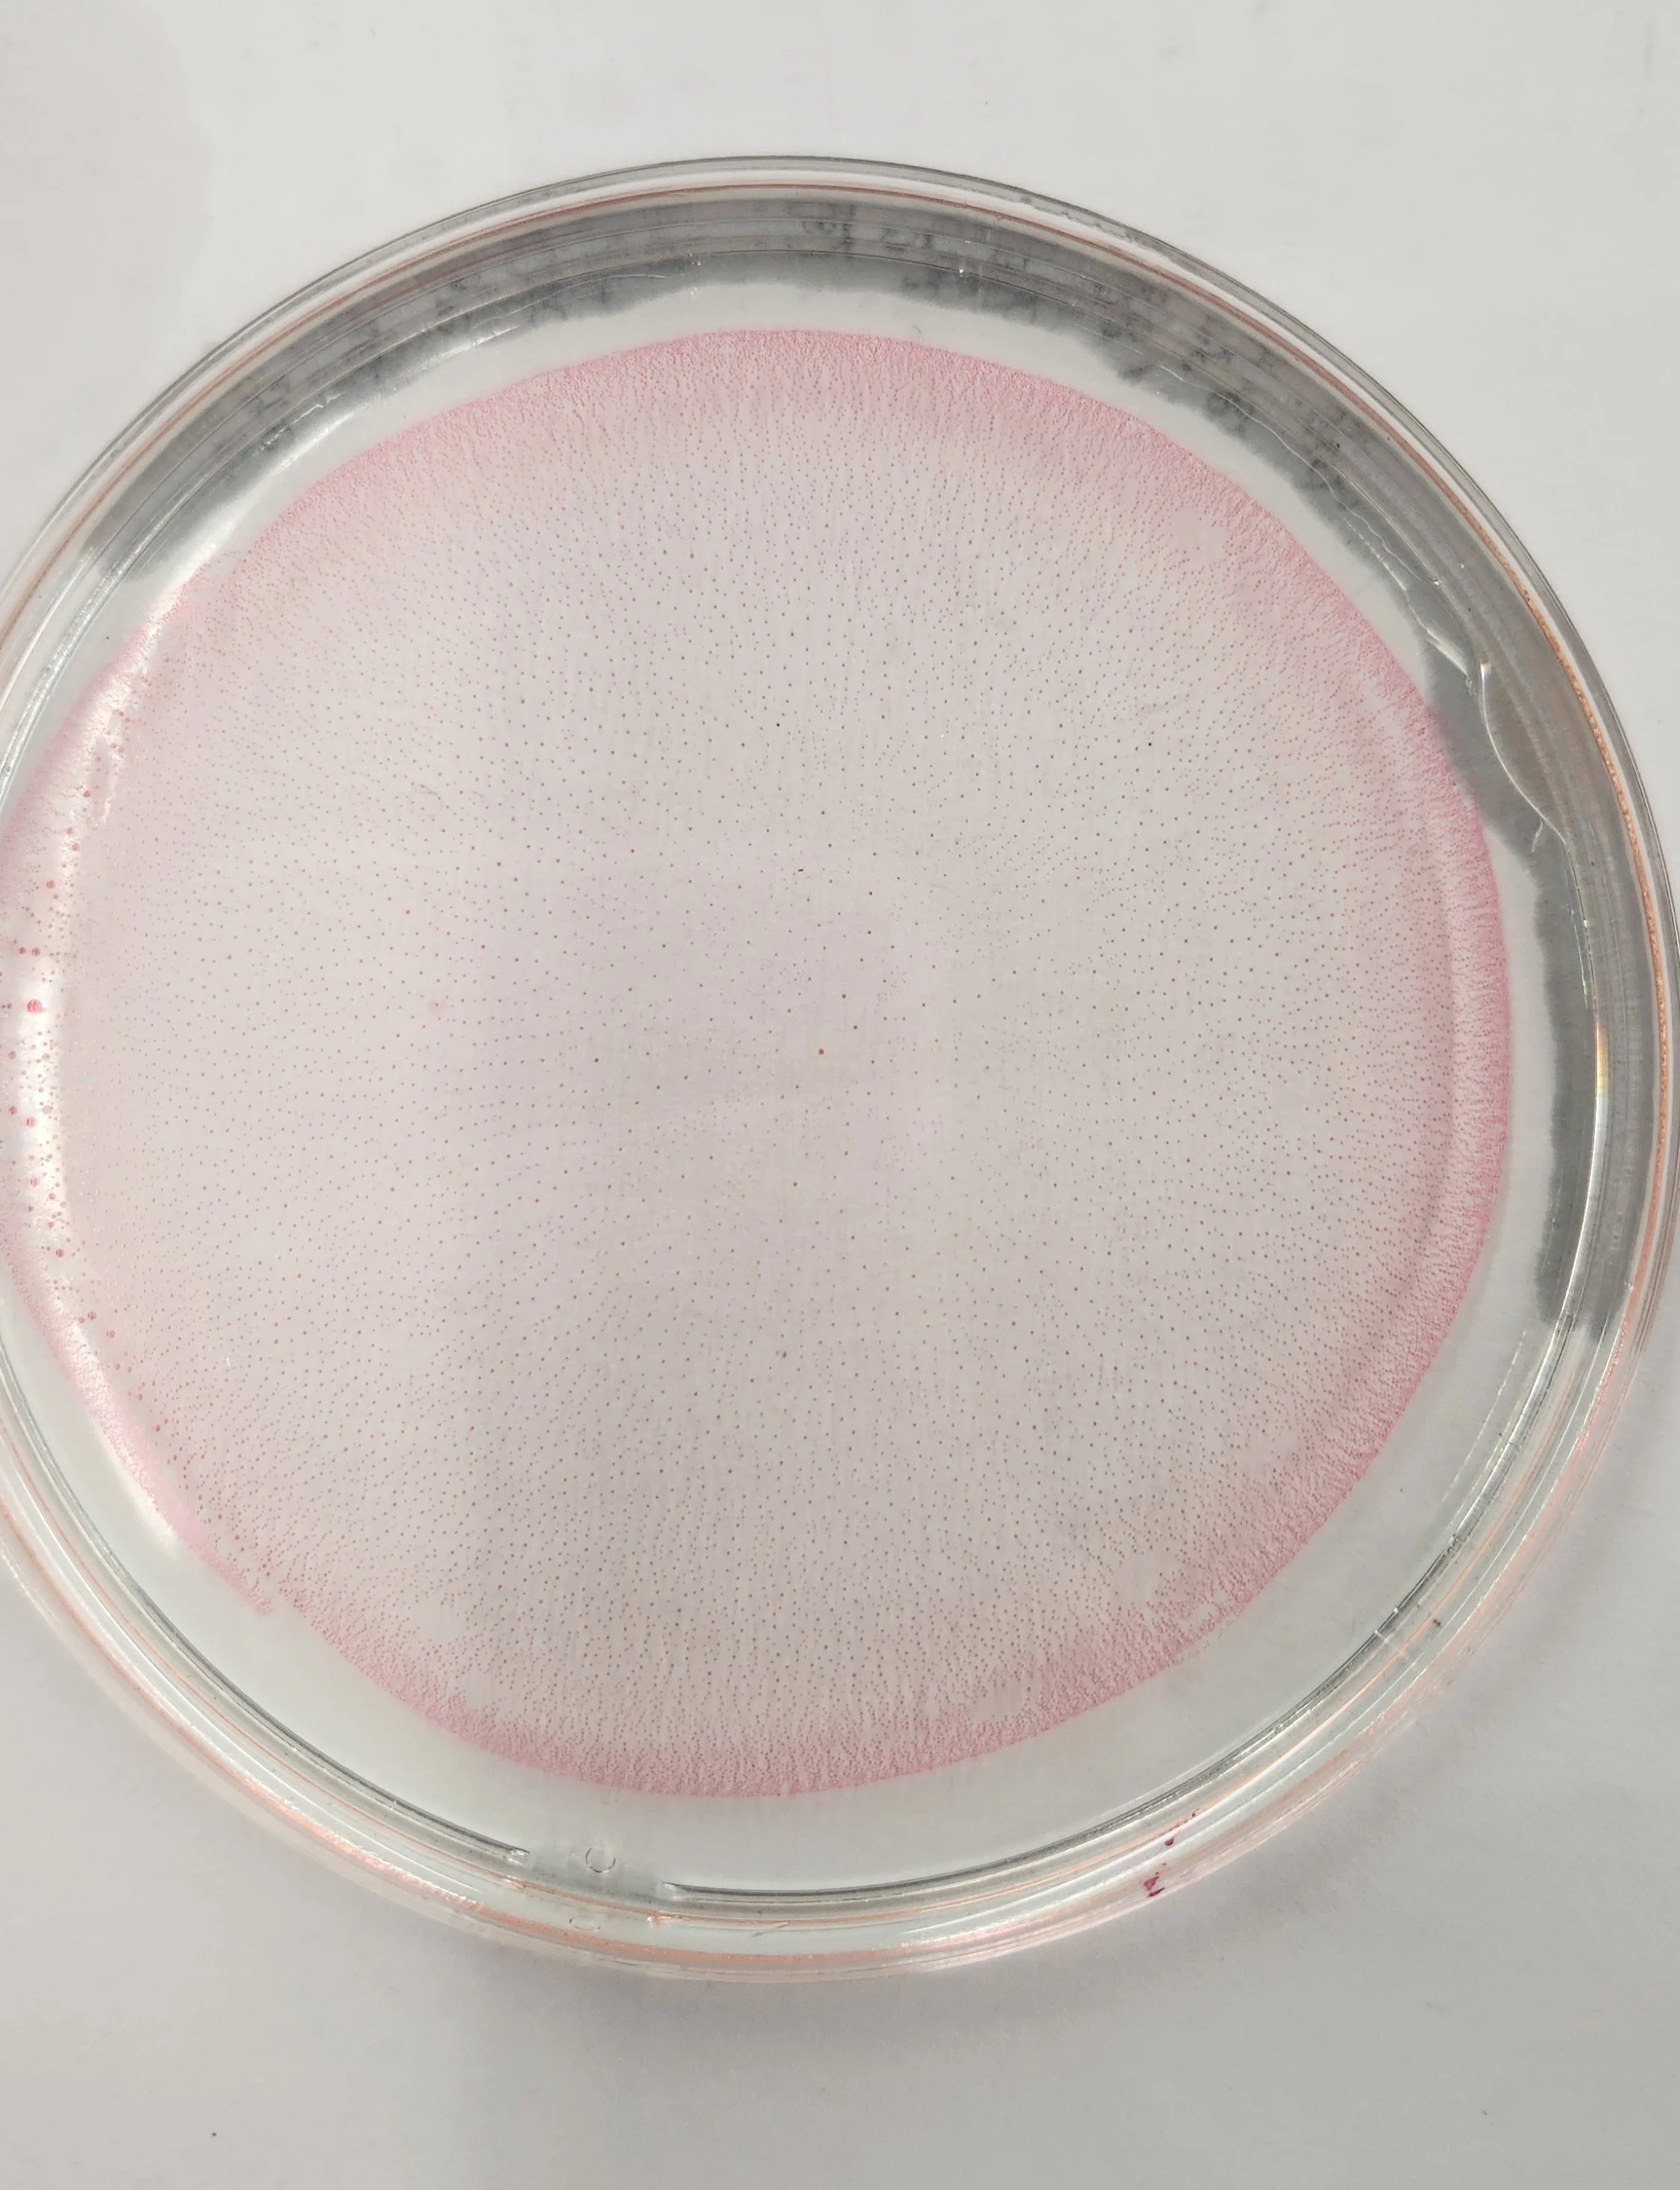
Marangoni D
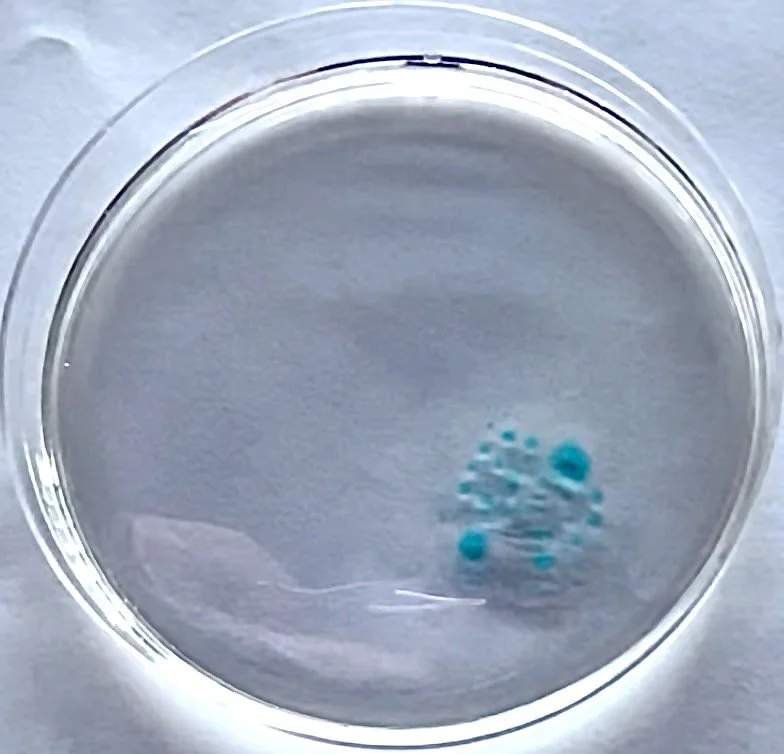
Marangoni E
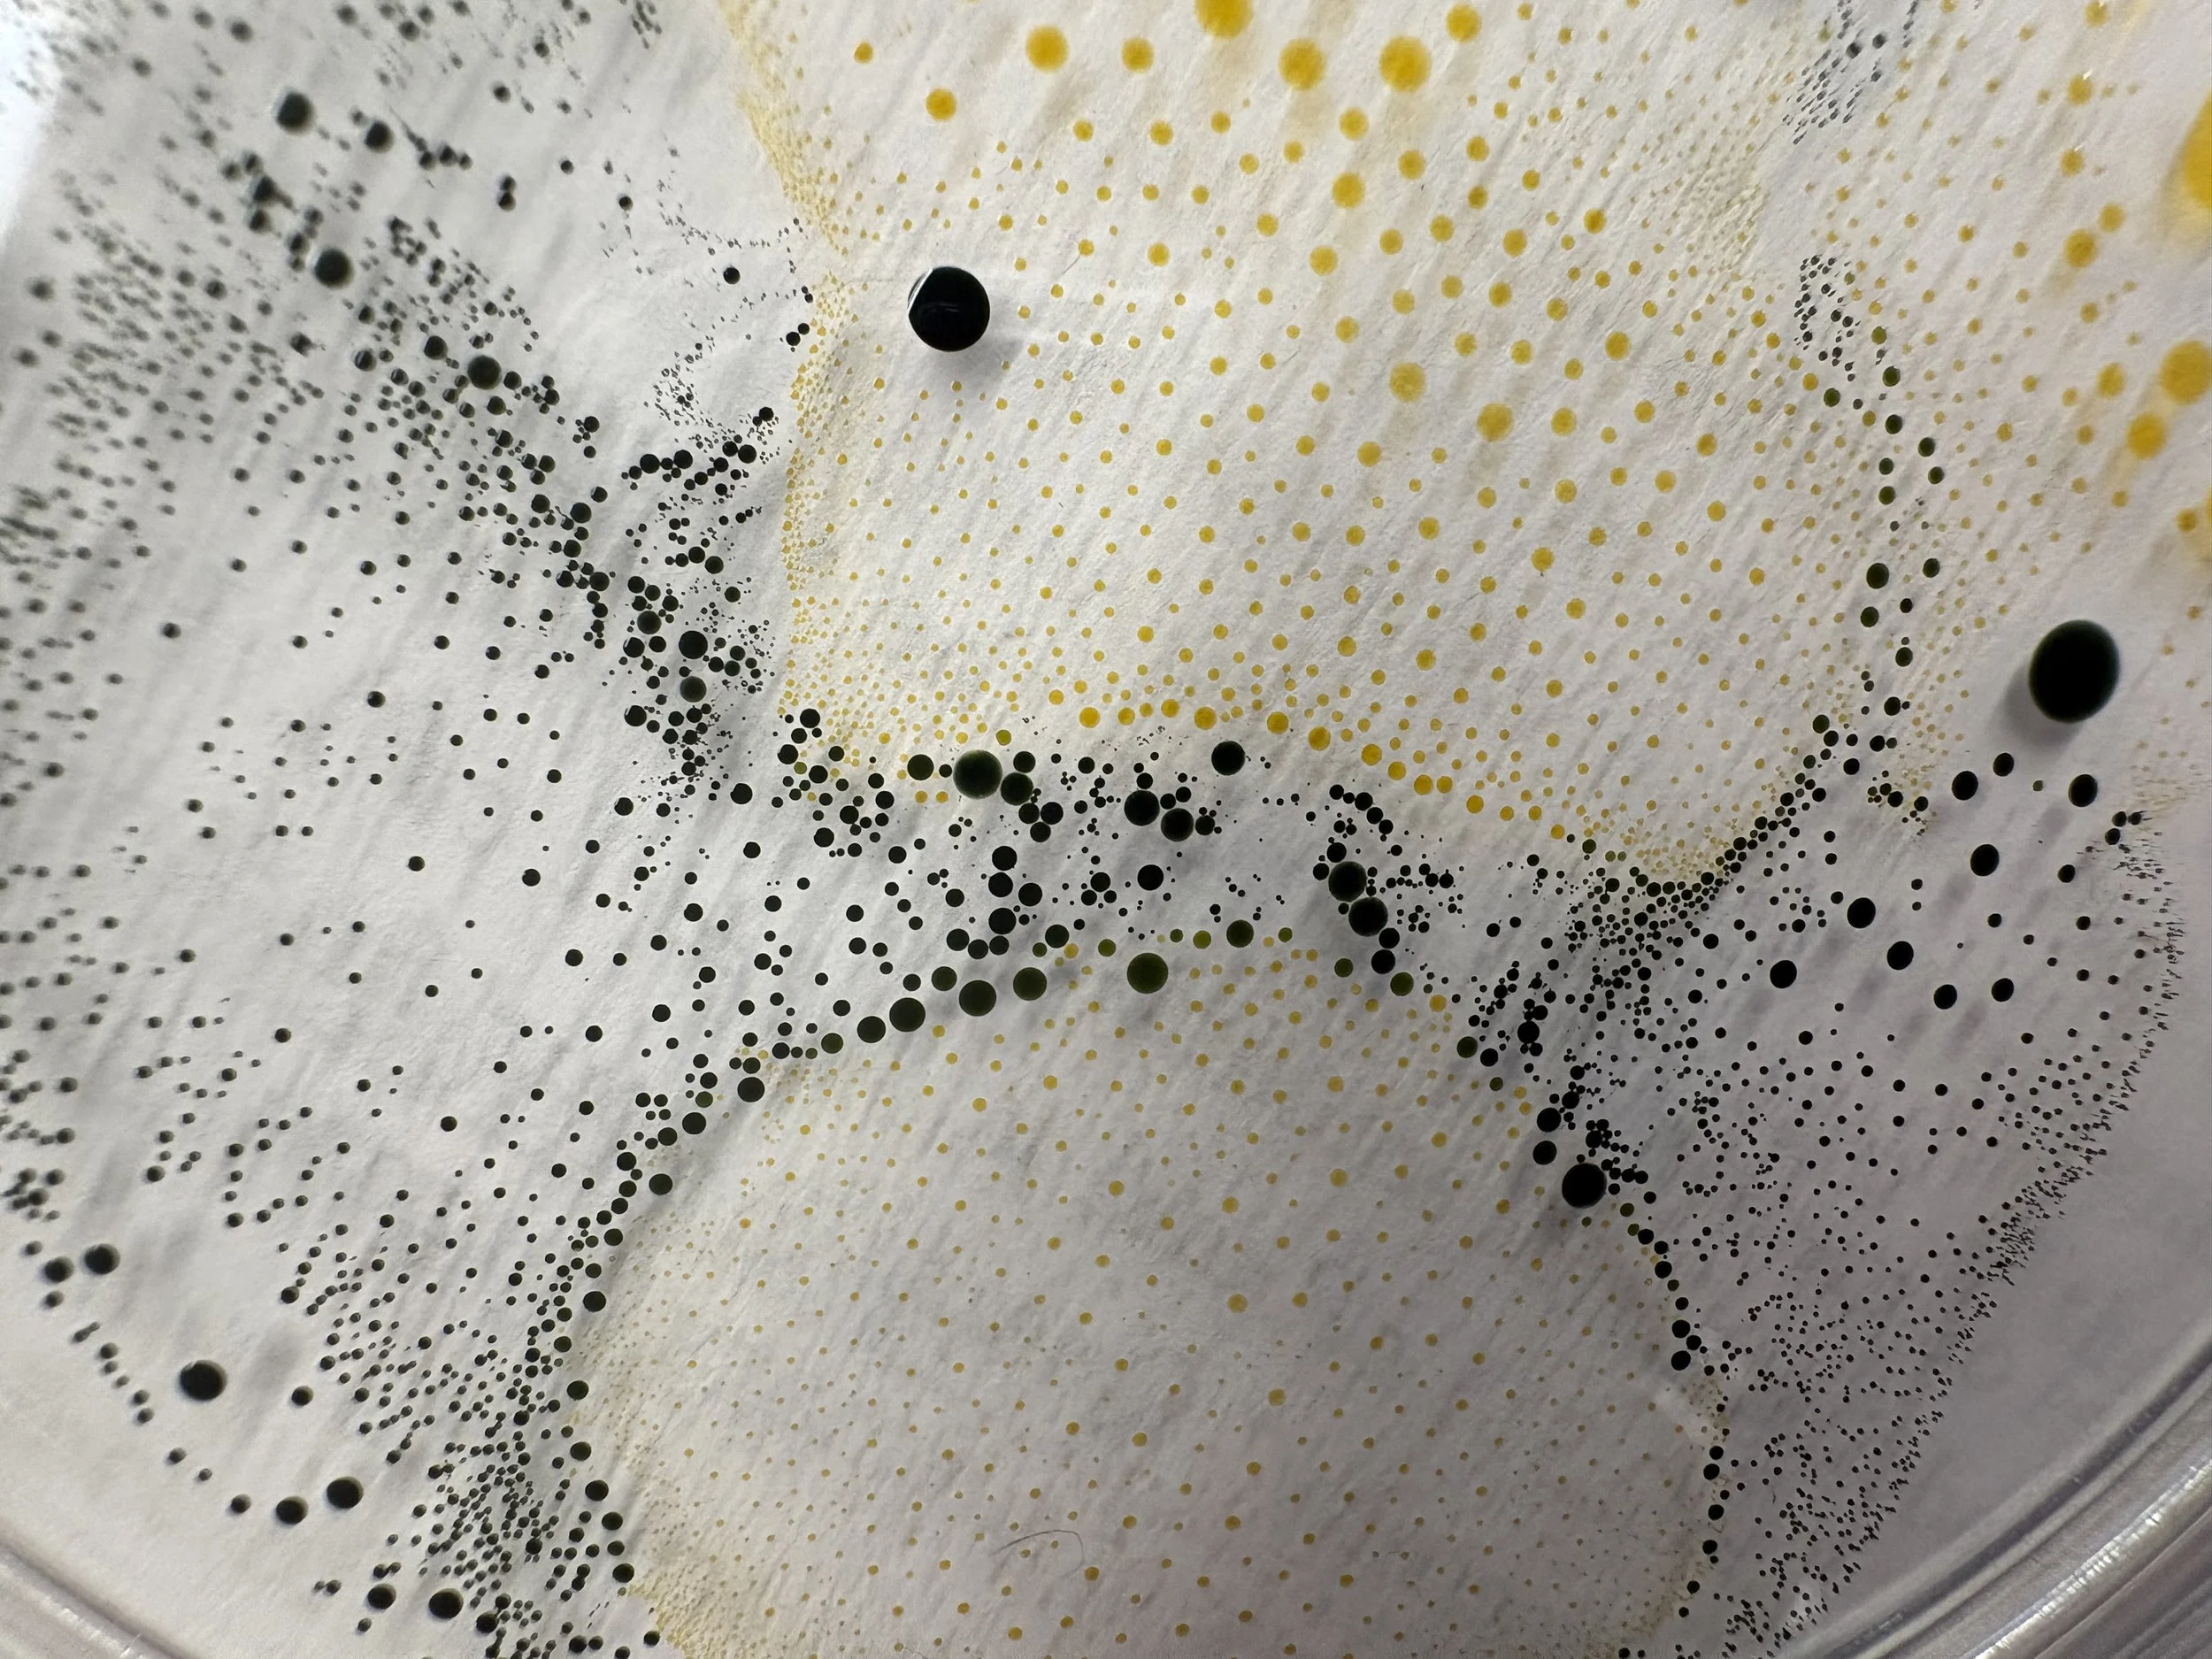
Marangoni M
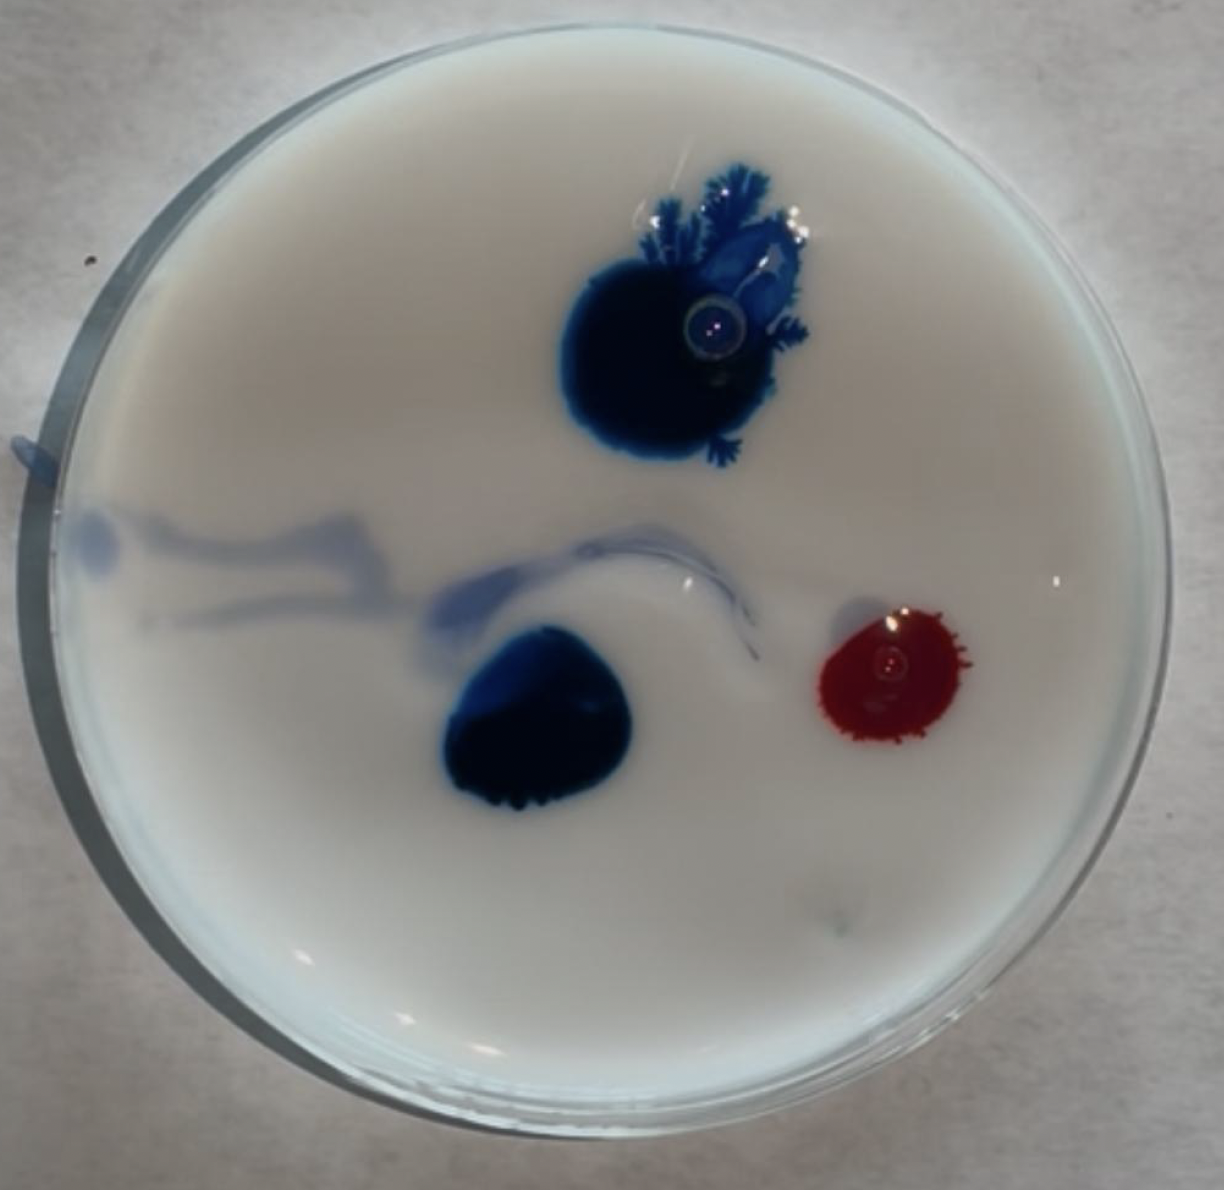
Saffman-Taylor B
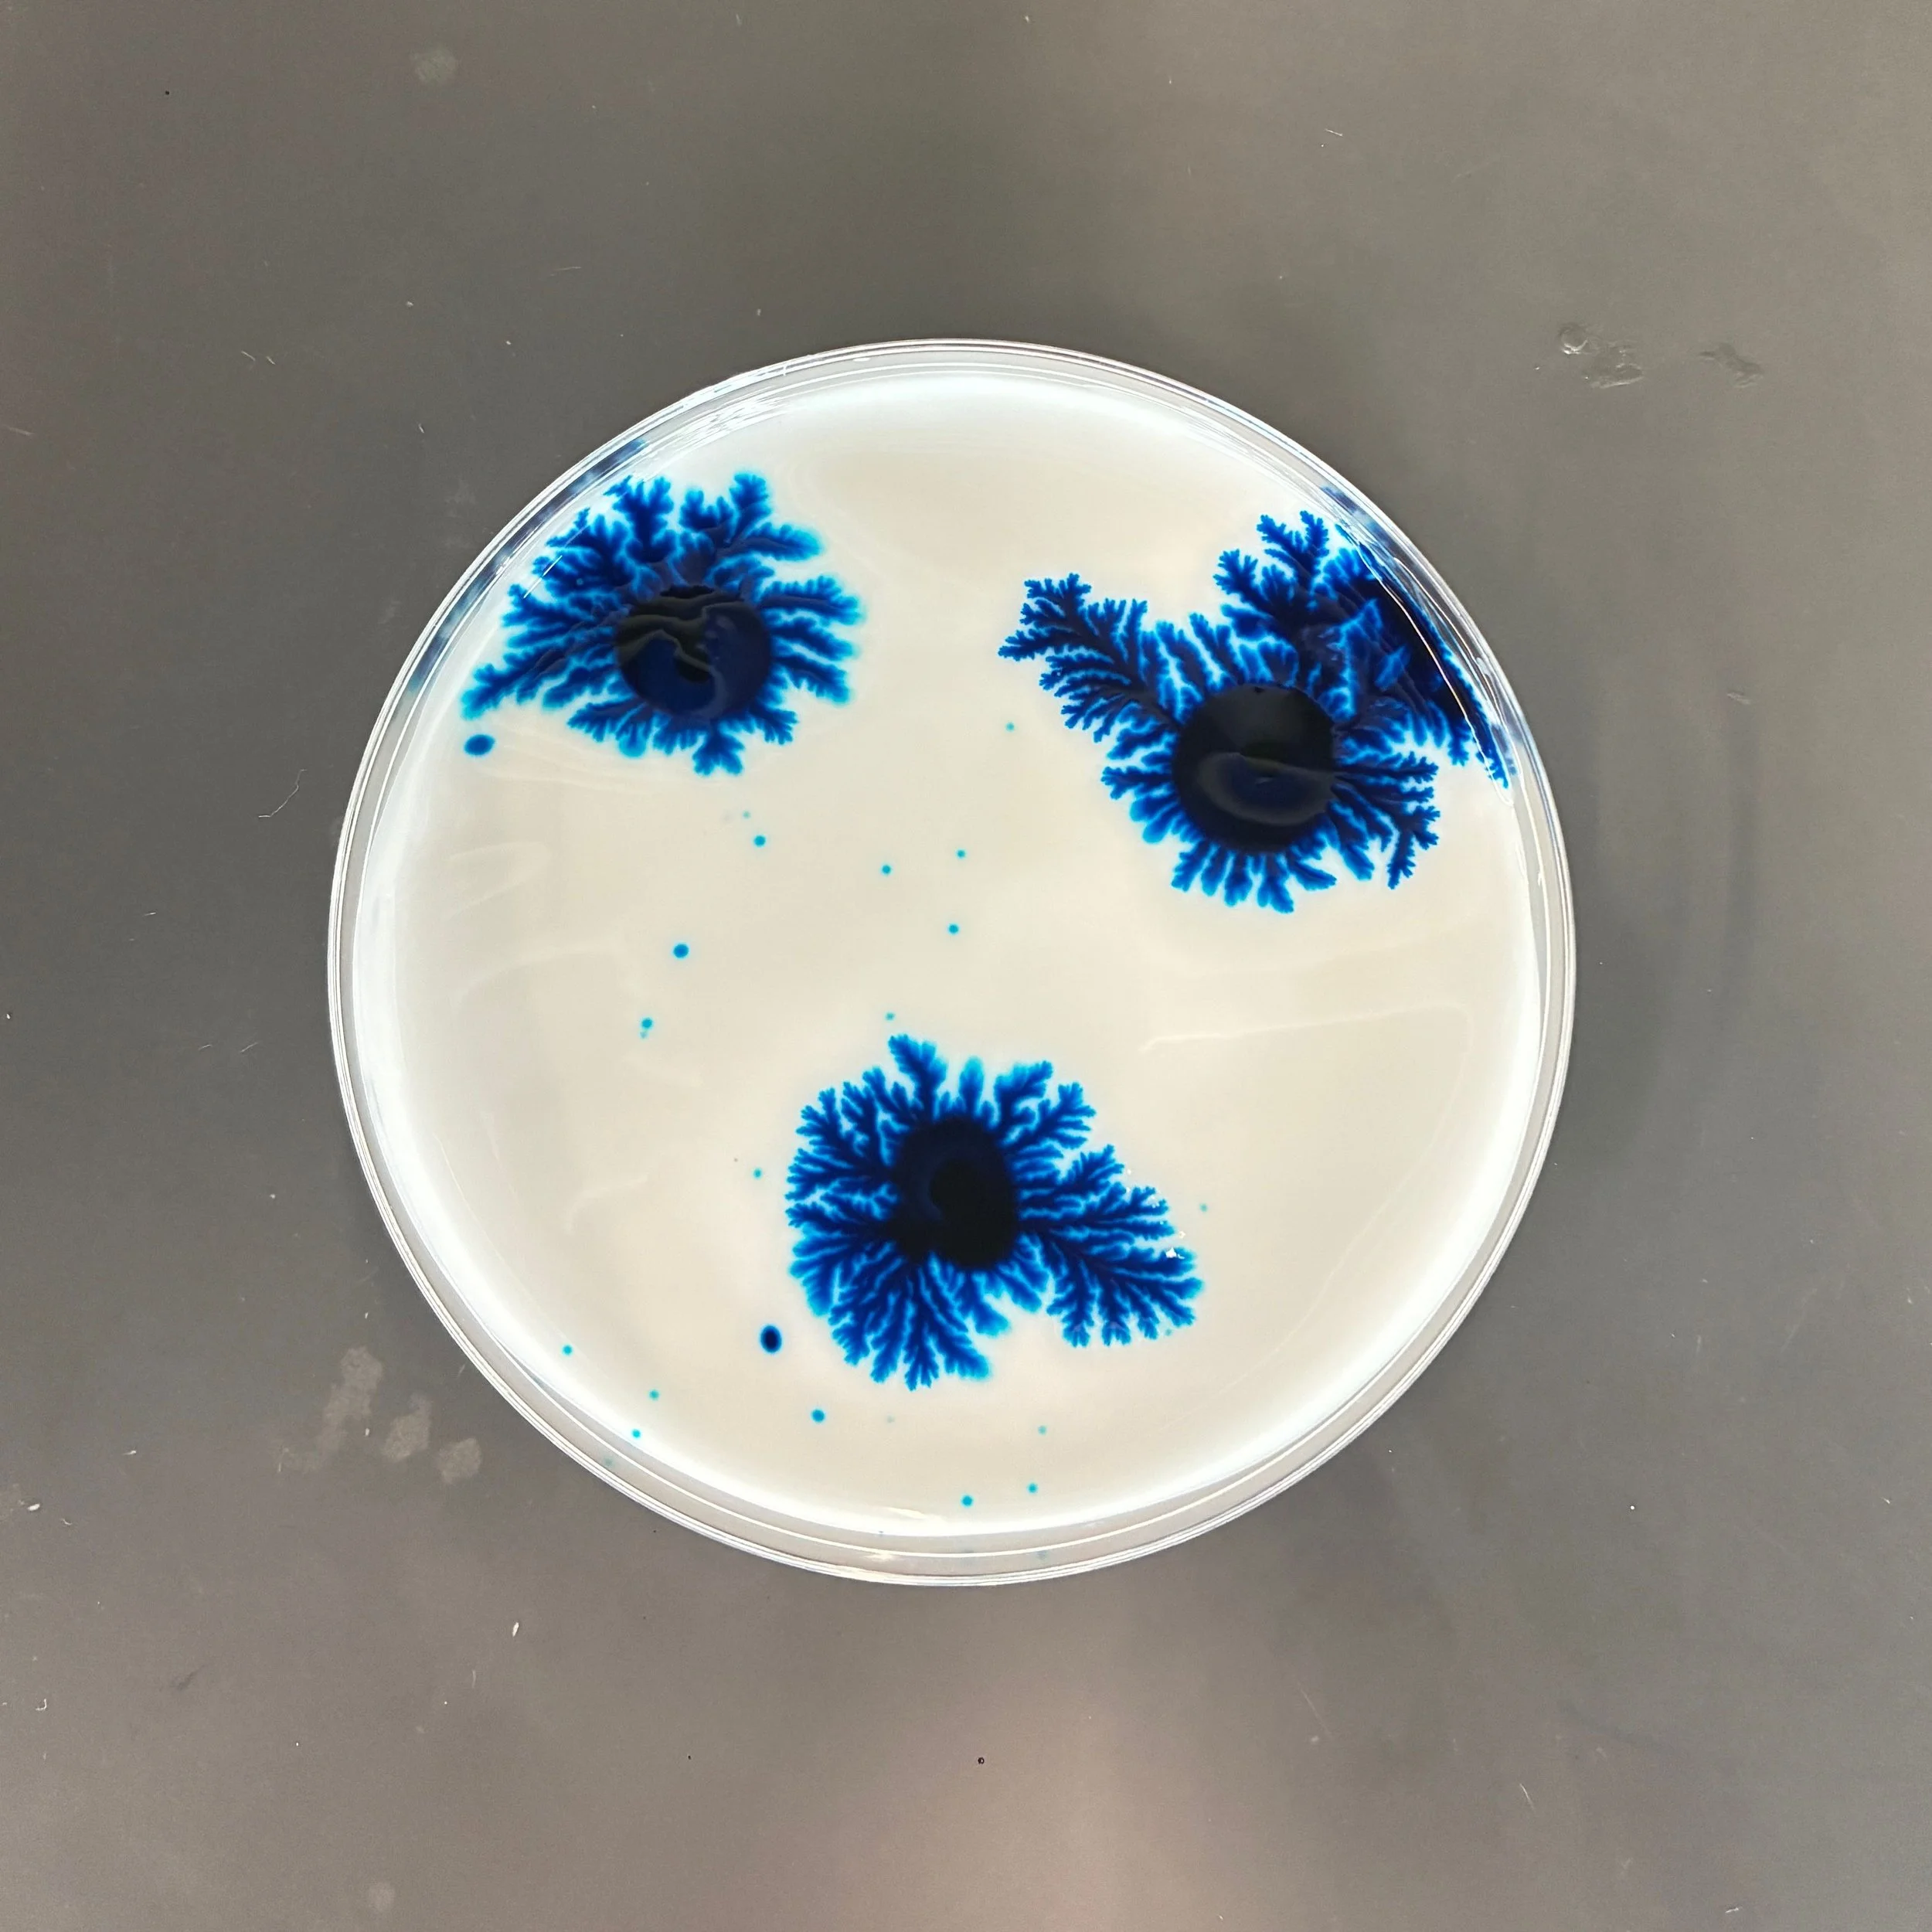
Saffman-Taylor F
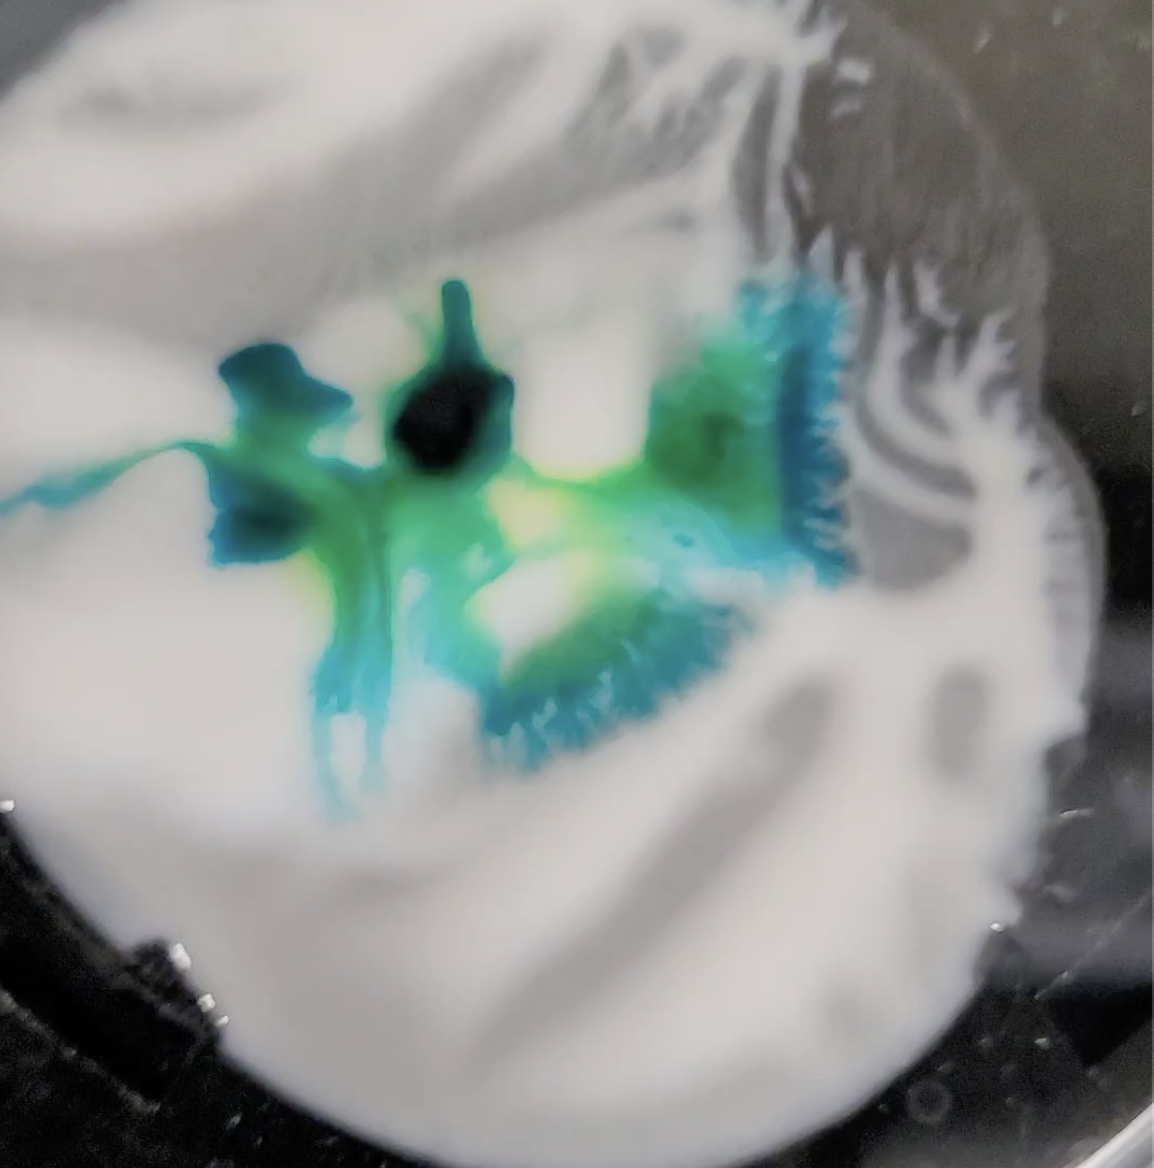
Saffman-Taylor I
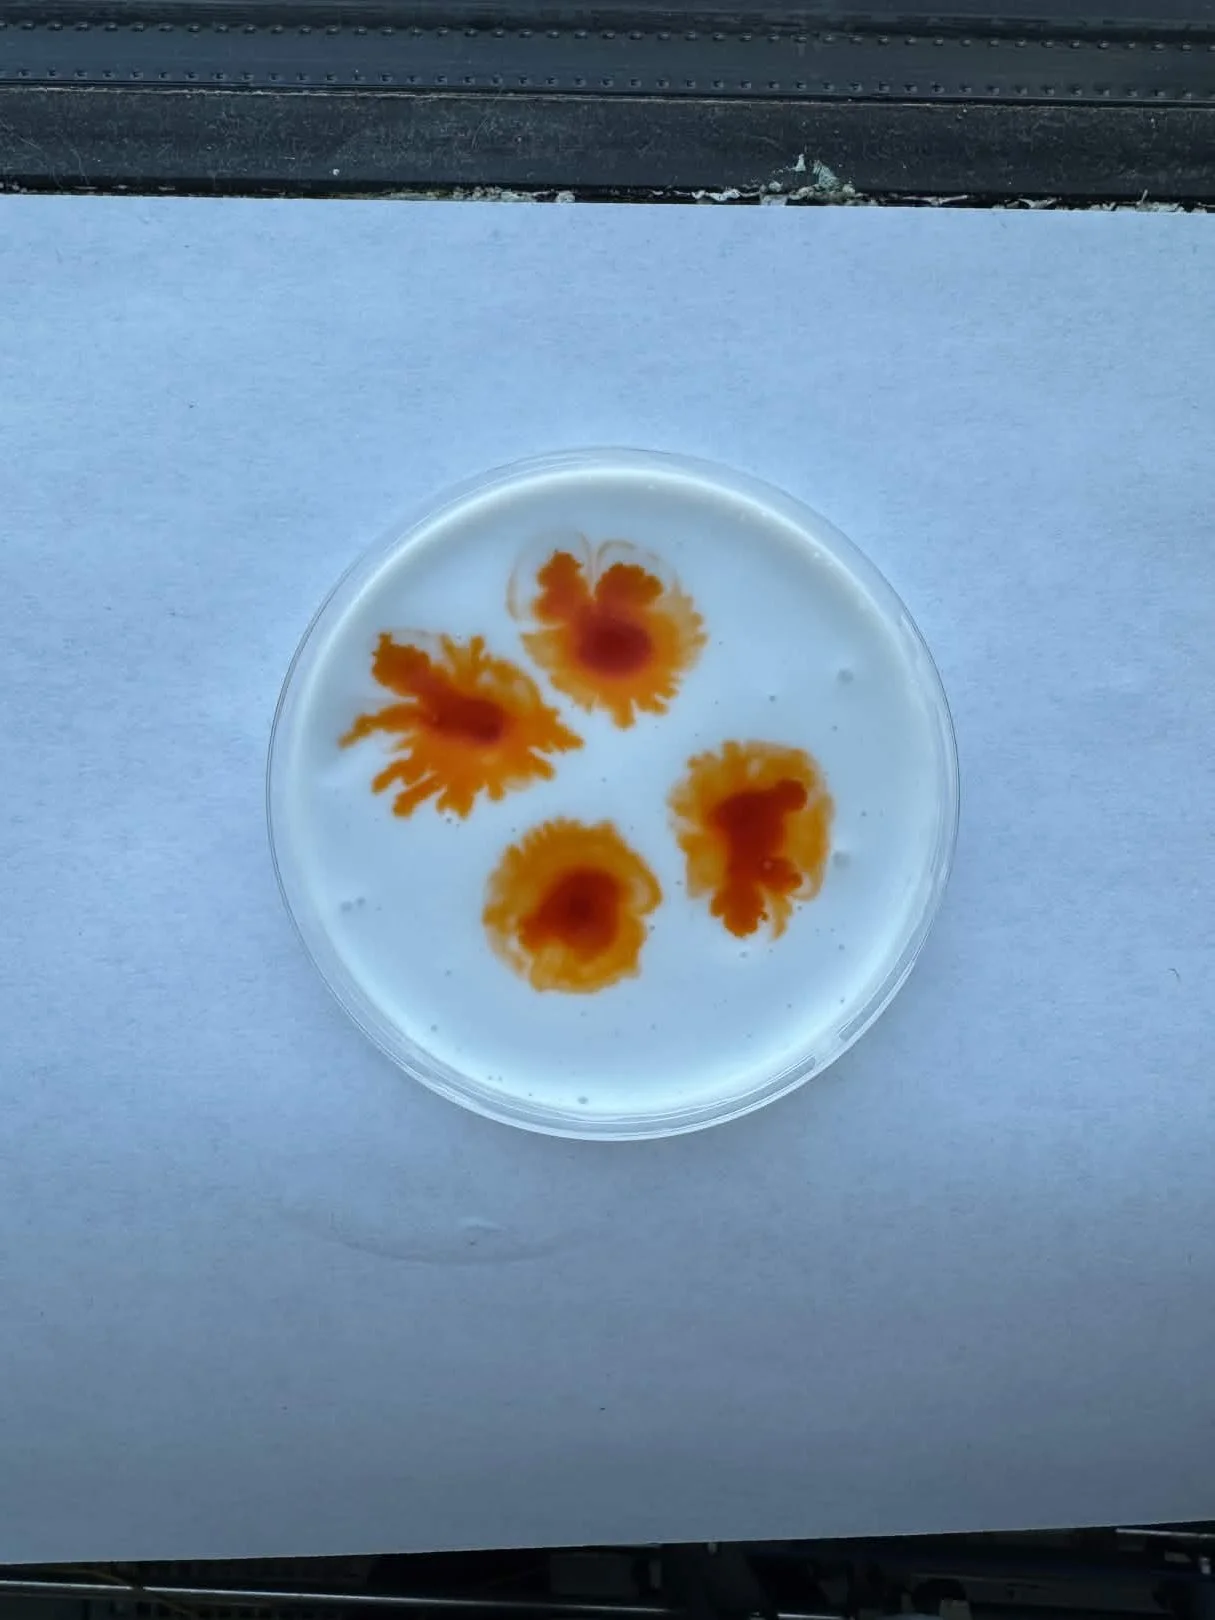
Saffman-Taylor AA
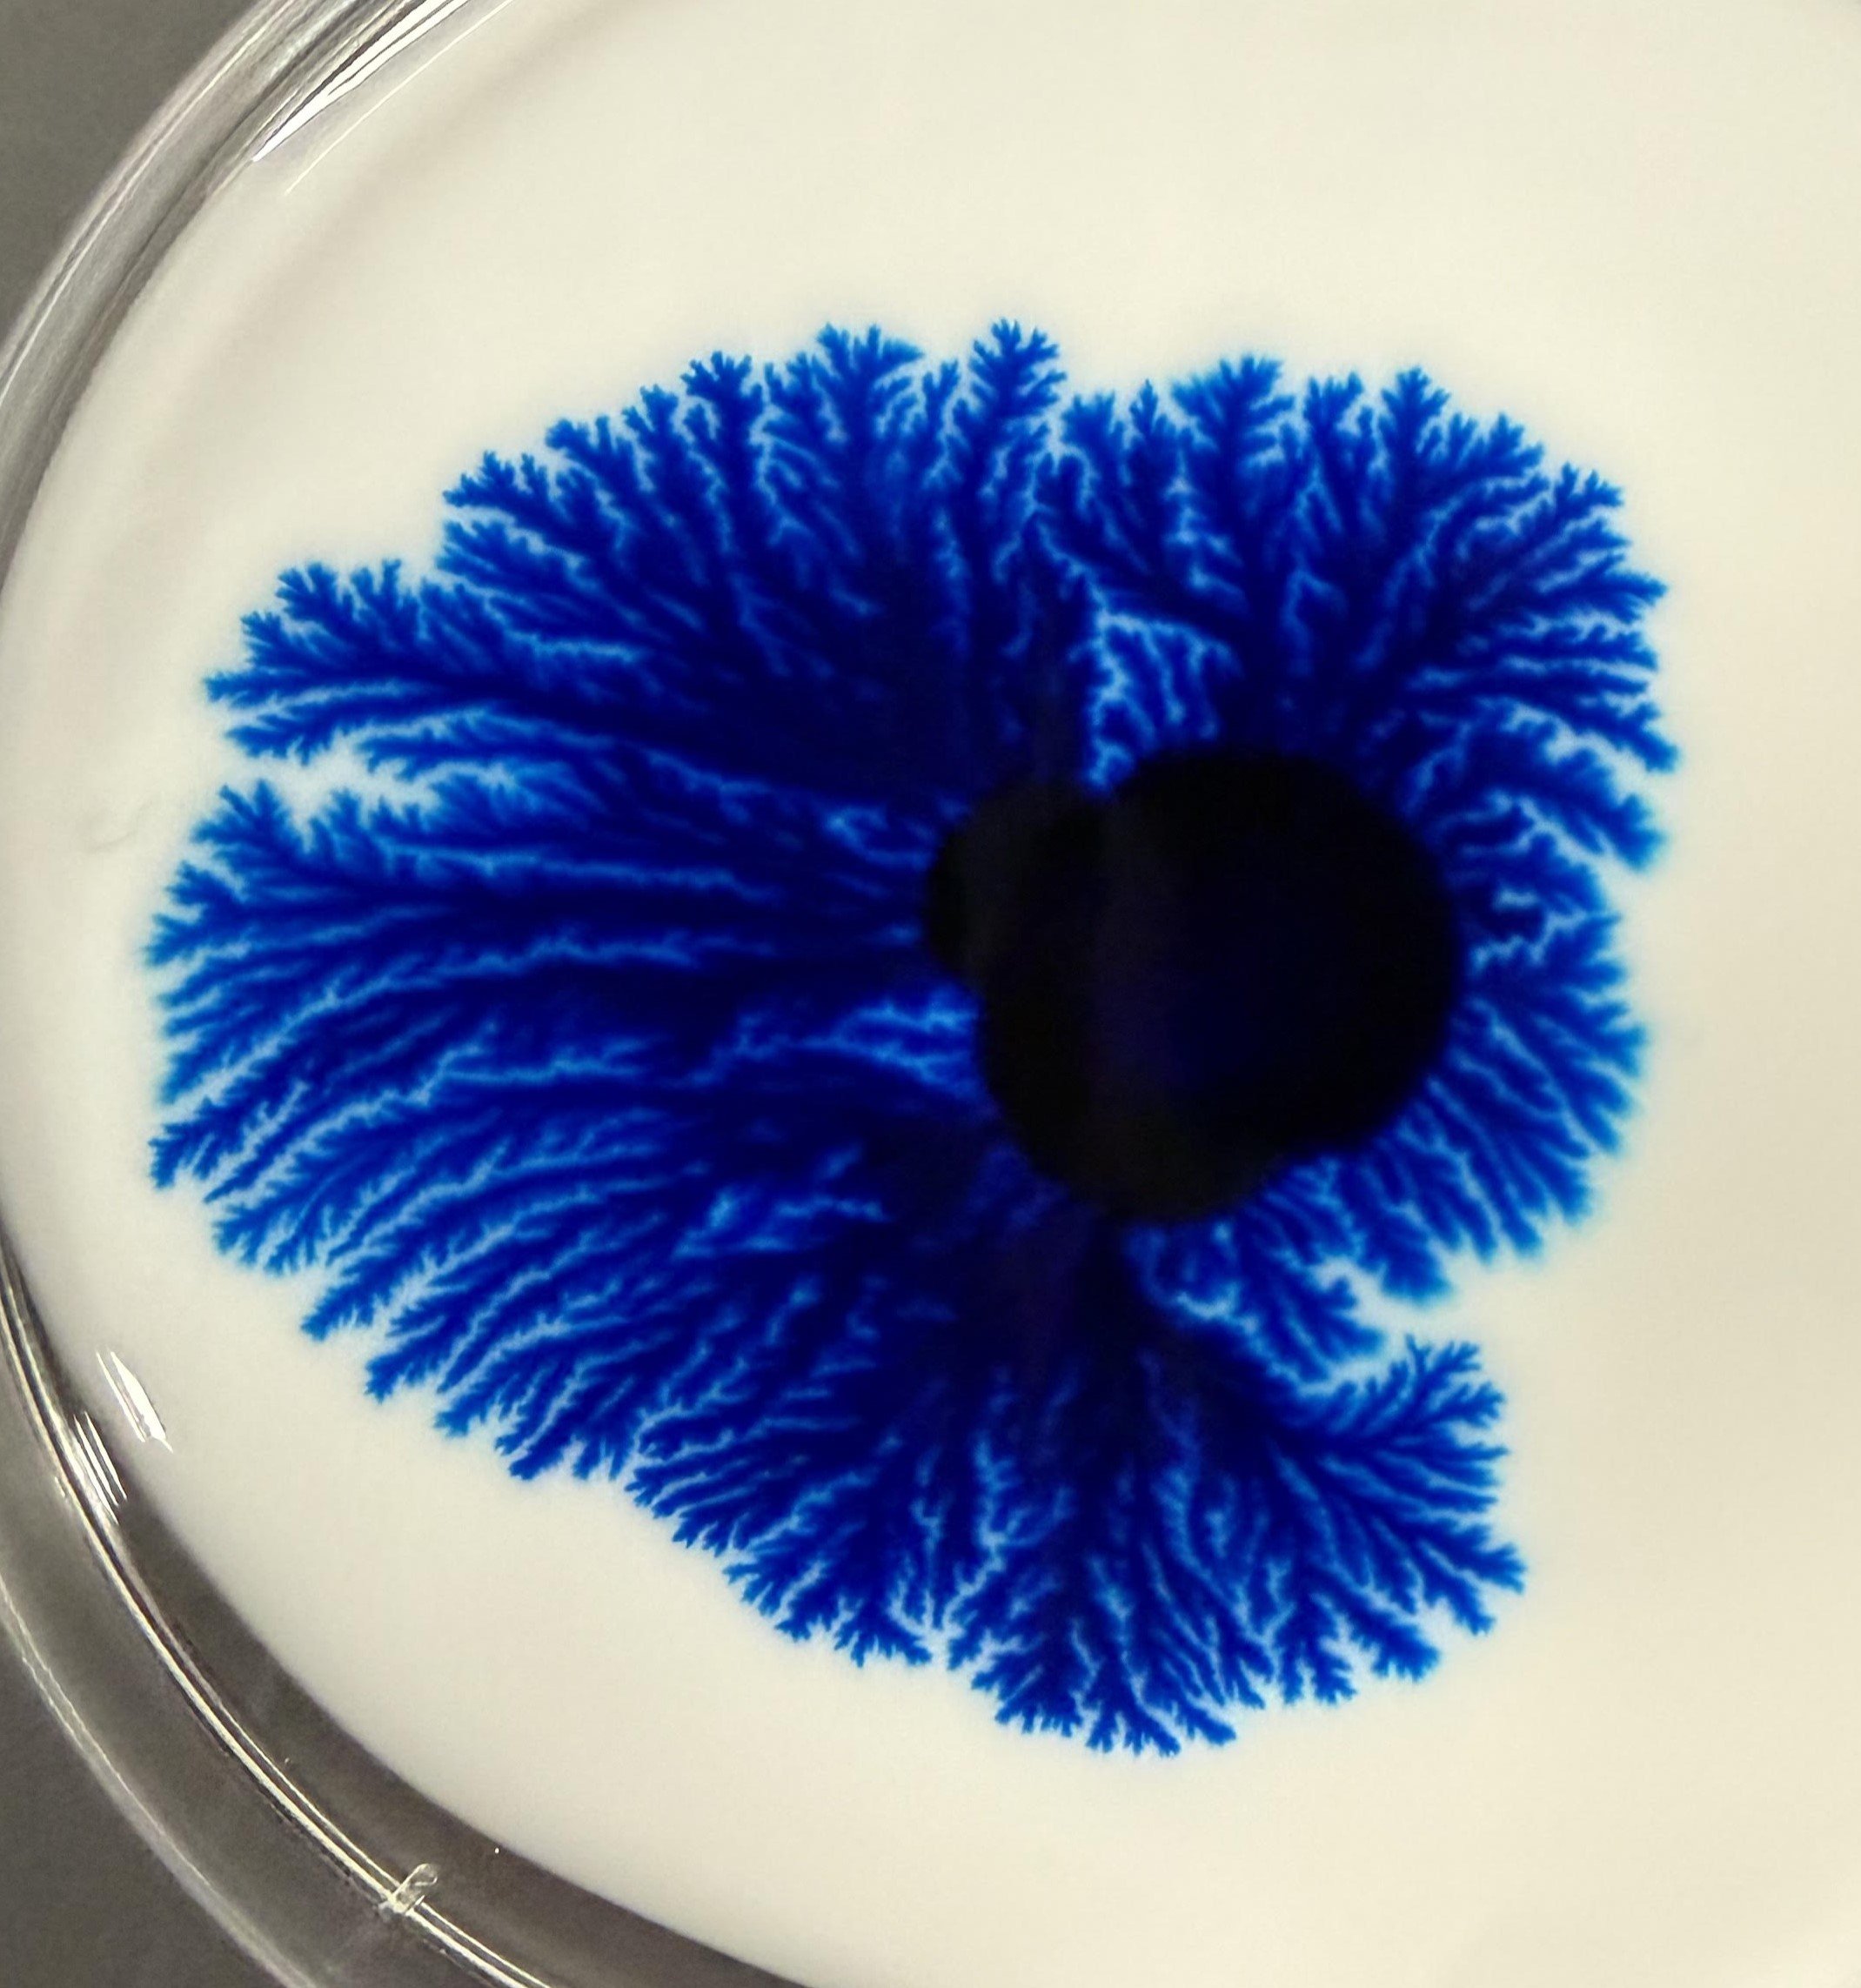
Saffman-Taylor DD

Visualizing Fluid Instability
This semester Oakland University's Introduction to Fluid Mechanics course, in collaboration with SUNY Polytechnic, explored fluid visualization of fluid instabilities. The images produced by students are shown, organized by instability, below.
Ferrofluids
Ferrofluids are fluids that contain a suspension of ferrous nanoparticles. This allows them to respond to magnetic fields.
Ferrofluid A

Ferrofluid B

Ferrofluid C

Ferrofluid D

Ferrofluid E

Ferrofluid F

Ferrofluid G

Ferrofluid H

Ferrofluid I
Marangoni Effect
This effect is observed at the interface of two fluids with different surface tensions.

Marangoni A

Marangoni B

Marangoni C
Marangoni D
Marangoni E

Marangoni F

Marangoni G

Marangoni H

Marangoni I

Marangoni J

Marangoni K

Marangoni L
Marangoni M

Marangoni N
Rayleigh—Bénard
Rayleigh—Bénard instability forms when a fluid is heated from below (and sometimes cooled from above). This heating causes the fluid density to decrease (and rise) and the cooler higher fluid to fall. This is a form of natural convection.
Rayleigh-Bénard A
Rayleigh-Bénard B
Rayleigh-Bénard C
Rayleigh-Bénard D
Rayleigh-Bénard E
Rayleigh-Bénard F
Rayleigh-Bénard G
Rayleigh-Bénard H
Rayleigh-Bénard I
Rayleigh-Bénard J
Rayleigh-Plateau
This instability explains why falling streams of fluids break up into smaller droplets—essentially to minimize their energy state due to surface tension.

Rayleigh-Plateau A
Rayleigh—Taylor
The Rayleigh—Taylor instability forms when a denser fluid is placed atop a less dense fluid. This causes the formation of spikes and bubbles as the ‘heavier’ fluid tries to move downward and the ‘lighter’ fluid tries to move upward.

Rayleigh-Taylor A

Rayleigh-Taylor B

Rayleigh-Taylor C

Rayleigh-Taylor D

Rayleigh-Taylor E

Rayleigh-Taylor F

Rayleigh-Taylor G

Rayleigh-Taylor H

Rayleigh-Taylor I

Rayleigh-Taylor J

Rayleigh-Taylor K

Rayleigh-Taylor L

Rayleigh-Taylor M

Rayleigh-Taylor N

Rayleigh-Taylor O

Rayleigh-Taylor P
Saffman—Taylor
Saffman—Taylor instability can be observed when a less viscous fluid is forced into a more viscous fluid. This instability gives rise to fractal patterning referred to as ‘viscous fingering’.

Saffman-Taylor A
Saffman-Taylor B

Saffman-Taylor C

Saffman-Taylor D

Saffman-Taylor E
Saffman-Taylor F

Saffman-Taylor G

Saffman-Taylor H
Saffman-Taylor I

Saffman-Taylor J

Saffman-Taylor K

Saffman-Taylor L

Saffman-Taylor M

Saffman-Taylor N

Saffman-Taylor O

Saffman-Taylor P

Saffman-Taylor Q

Saffman-Taylor R

Saffman-Taylor S

Saffman-Taylor T

Saffman-Taylor U

Saffman-Taylor V

Saffman-Taylor W

Saffman-Taylor X

Saffman-Taylor Y

Saffman-Taylor Z
Saffman-Taylor AA

Saffman-Taylor BB

Saffman-Taylor CC
Saffman-Taylor DD

Saffman-Taylor EE

Saffman-Taylor FF

Saffman-Taylor GG










